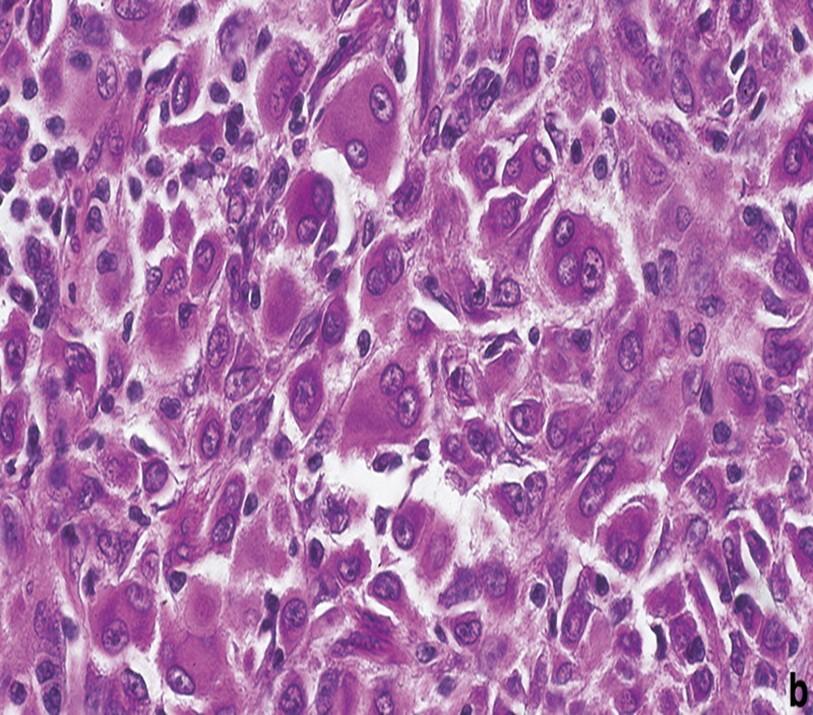

2 minute read
LA PIEL TIENE MÚLTIPLES FUNCIONES
• Barrera protectora
• Absorbe y elimina líquidos
Advertisement
• Regula la temperatura
• Impide la perdida y entrada del agua
• Absorbe y filtra radiaciones
• Tiene funciones sensitivaS
• Impide la entrada de microorganismos
Estructrura
(faneras)
DE LA PIEL Y LOS ANEXOS
• El sistema tegumentario está integrado por la piel y por los anexos o faneras, conjuntos de estructuras derivados de los mismos esbozos embriológicos que original la piel.
• La piel está constituida por 3 capas: un epitelio, la epidermis, que es el tejido especializado característico de este órgano y su parte más externa; un tejido conjuntivo, la dermis, por debajo del anterior; y la hipodermis, su capa más profunda
Epidermis
• Epitelio escamoso estratificado con estrato corneo.
• Está formado´ por 5 capas o estratos celulares:
• Estrato basal (germinativo), estrato espinoso, estrato granuloso estrato lucido y estrato corneo
Dentro de sus capaz, se presentan 4 tipos celulares: Queratinocitos, melanocitos, células de Langerhans y células de Merkel
Queratinocito
• Se descaman de la superficie de la piel.
• Llevan el nombre porque acumulan filamentos de queratina en su citoplasma (filamentos intermedios).
• Representan alrededor del 90% de las células epidérmicas.

• Su actividad mitótica se da en las capas basales, principalmente realizan mitosis durante la noche.
• Mueren y se descaman en un proceso que requieren 20 a 30 días.
Melanocitos

• Es una célula dendrítica, que tiene como misión la fabricación de pimento melánico por medio de la metalogénesis.
• La función de la melanina incluye la resistencia a los efectos de la radiación ultravioleta, el control de la síntesis de la vitamina D y la termorregulación local.
Celula De Langerhans
• Son células presentadoras de antígeno, se hallan ubicadas entre los queratinocitos del estrato espinoso.
• Se originan en la medula ósea y actúan como células dendríticas. Participan en la respuesta inmunitaria contra los microorganismos que invaden la piel y son sensibles a la luz UV.
• Su función en la respuesta inmunitaria consiste en ayudar a otras células del sistema inmunitario a reconocer microorganismos invasores y destruirlos

• Se reemplazan de manera continua por células precursoras que salen del torrente sanguíneo para ingresar a la epidermis.
Celula De Merkel
• Es la célula que tiene una función mecano receptora, estando localizada en lugares con sensibilidad táctil muy intensa como son los pulpejos, mucosas y folículo piloso, se asocia a terminaciones nerviosas intradérmicas
Estrato Basal
• en forma continua. Es la capa más profunda de la epidermis, también conocida como estrato germinativo por su papel en la formación de células nuevas.

• Este compuesto por una sola hilera de queratinocitos cúbicos o cilíndricos con baja actividad mitótica.
• El cito esqueleto de los queratinocitos del estrato basal está formado por filamentos intermedios de queratina (tono filamentos
• Estos filamentos constituyen la proteína queratina resistente de las capaz epidérmicas más superficiales. La queratina protege a las capas más profundas de la lesión.
• Se une a ellos mediante desmosomas y con la membrana basal mediante hemidesmosomas.
• Algunas células madre de dividen para formar queratinocitos nuevos
Capas De La Epidermis


Estrato espinoso
• Capa más superficial con respecto al estrato basal. Sus células presentan numerosas prolongaciones, lo que le da un aspecto espinoso.
• Contiene numerosos queratinocitos dispuestos en 8 a 10 capas. Los de las capas más superficiales son algo aplanados